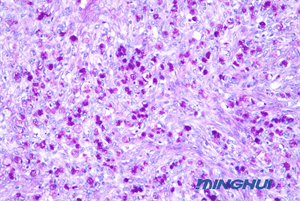
生物显微镜NE710+ MHD2000用于医院病理检验2.jpg

应用案例
Application Case
专业显微镜方案提供商
实验教学 医学检验 生命科学研究 工业领域
实验教学 医学检验 生命科学研究 工业领域
广州明慧科技推出的生物显微镜NE710与显微镜摄像头MHD2000组合,广东某医院病理科引进了这套设备,试机过程中,实验老师对这套设备的表现效果尤为满意,图像的高清晰度与色彩还原度,提升了病理检验的准确性和效率。

NE710显微镜采用了NIS无限远光学系统,提供优秀的可扩展性,确保成像质量。高数值孔径(NA) 和长工作距离,成像清晰度高,适用范围广,还原真实色彩,实现对样本的准确观察。

显微镜前端的液品屏幕能够显示显微镜的使用状态,包括倍率、光照强度、色温、待机状态等,提供舒适的用户体验。内置摄像装置,配套安卓、iOS、windows 操作系统,有线和 WIFI两种模式。可以将显微镜下的图像高清实时输出到外部设备,并且没有数据线连接,操作者行动更加自由。

MHD2000显微镜摄像头以其2000万的有效像素、高分辨率和高对比度,接近目镜的色彩表现,USB3.0的高速数据传输接口,确保了图像的高清晰度与色彩还原度,使得观测结果更加准确可靠,为病理检验提供了精准可靠的图像支持。
在实际应用中,这套设备帮助病理科准确识别了多种疾病的病理特征,特别是在肿瘤和感染性疾病的诊断中,发挥了重要作用。实验老师表示,使用这套设备后,病理检验的准确性和效率都有了显著提升。

广州明慧生物显微镜NE710与显微镜摄像头MHD2000的组合,以其卓越的性能和精准的观测能力,赢得老师的好评,成为医院病理检验的重要工具,也为医学研究和临床教学提供了有力支持。

热线020-87096762

致电13418179239

